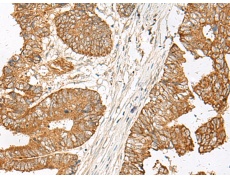
一抗

|
Background: |
Transducin is a 3-subunit guanine nucleotide-binding protein (G protein) which stimulates the coupling of rhodopsin and cGMP-phoshodiesterase during visual impulses. The transducin alpha subunits in rods and cones are encoded by separate genes. This gene encodes the alpha subunit in rods. This gene is also expressed in other cells, and has been implicated in bitter taste transduction in rat taste cells. Mutations in this gene result in autosomal dominant congenital stationary night blindness. Multiple alternatively spliced variants, encoding the same protein, have been identified. |
|
Applications: |
ELISA, WB, IHC |
|
Name of antibody: |
GNAT1 |
|
Immunogen: |
Synthetic peptide of human GNAT1 |
|
Full name: |
G protein subunit alpha transducin 1 |
|
Synonyms: |
GBT1; GNATR; CSNB1G; CSNBAD3 |
|
SwissProt: |
P11488 |
|
ELISA Recommended dilution: |
5000-10000 |
|
IHC positive control: |
Human colorectal cancer |
|
IHC Recommend dilution: |
30-150 |
|
WB Predicted band size: |
40 kDa |
|
WB Positive control: |
HT29 cell lysate |
|
WB Recommended dilution: |
500-2000 |


 購物車
購物車 幫助
幫助
 021-54845833/15800441009
021-54845833/15800441009